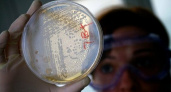
«Рекомендуем пить кипяченую воду»: в Роспотребнадзоре Новороссийска прокомментировали ситуацию с эпидемией кишечной инфекции в станице Раевской

Новости по тэгу Новороссийск
Последние новости
Как в СССР: россияне массово возвращаются к забытой схеме покупки жилья
03:02Не выливайте воду после яиц: бабушкин секрет, который заставит цвести цветы и отбелит бельё без химии
02:46Выбросьте хлорку: залейте в унитаз этот фруктовый сок — и он побелеет через 2 минуты
02:09Собственникам трёх и более квартир готовят сюрприз: налоговая нагрузка может вырасти
01:38Проверьте квитанции ЖКХ: вы могли годами платить за магазины и аптеки в вашем доме
01:03Не только для ветеранов: новый вид пенсии назначат с 3 апреля — кто в списке
00:41Срочно проверьте забор на даче: штраф 5000 рублей и снос за ошибку, о которой многие не знают
00:07Выбросьте пемзу: 30 минут в кефире — и пятки станут нежнее шелка, натоптыши отвалятся сами
ВчераВсего 2 горсти на грядку — и картошка вырастет с грейпфрут: дешевле навоза в 5 раз, пользы в 10
ВчераНе покупайте ядохимикаты: как советский настой сжег всю тлю на участке за 2 дня
ВчераНовороссийцу не понравилось, как припаркована машина, и он решил ее «избить»
ВчераНамазала на ночь — и утром не узнала лицо: как это масло за 2 недели убрало пигментные пятна
Вчера«Машины обливают, лужа по щиколотку!»: в Новороссийске пешеходный переход перед остановкой затоплен грунтовыми водами
ВчераДобавьте этот секретный продукт в фарш — и котлеты будут брызгать соком: забудьте про сало и хлеб
ВчераПерестаньте варить свеклу в кастрюле: как приготовить идеальный борщ с ярким цветом и насыщенным вкусом
Вчера57 лет назад на улицы Новороссийска вышел первый «рогатый»: история троллейбуса и ретрофото
ВчераС 1 апреля пенсии вырастут на 6,8%, но не для всех: этот нюанс разделит получателей на две группы
ВчераВ Новороссийске «гаишники» устроили погоню за пьяным водителем на «Понтиаке»
ВчераВерните деньги за советский стаж: этот период до 2002 года часто пропускают при расчете пенсии — что делать в апреле
ВчераНе думайте даже: Омар Хайям назвал 3 запретные мысли, которые рушат жизнь
ВчераРастения Новороссийска оцифруют и оценят их состояние, прежде чем высаживать новые: в городе стартует проект «Зеленый каркас»
ВчераЗабудьте про ведро воды: этот трюк с тряпкой делает уборку в три раза быстрее
Вчера«Утром в город белой пушистой кошкой проскользнул туман»: атмосферная фотоподборка мистического природного явления
ВчераРеверс на два месяца: на серпантине между Новороссийском и Кабардинкой ремонтируют дорогу
ВчераХолодильник больше не воняет: натираю этим копеечным средством — и запахи не смешиваются, а продукты живут дольше
ВчераЭто не первоапрельская шутка: в Новороссийске отключили воду, когда дадут – неизвестно
ВчераВешать тюль на окна — колхоз: чем продвинутые хозяйки заменяют классические шторы в 2026
ВчераВ Новороссийске уже три недели ищут без вести пропавшего 44-летнего мужчину
ВчераДаже не думайте об этом: Омар Хайям назвал 3 фразы, которые притягивают беду — проверьте себя
ВчераЗачем покупать хамсу, мыться в тазике и бояться бороды: нейросеть придумала 15 искрометных шуток про Новороссийск
ВчераХлорку — на свалку: смешала два аптечных раствора — и плесень в ванной исчезла навсегда
ВчераСсора утихает за 10 минут: почему молчание работает лучше, чем тысяча слов
ВчераМиллион ярко-желтых солнышек: в Новороссийске в Цемесской роще зацвели лютики
ВчераКарандаш для бровей больше не нужен: мажу маслом раз в 3 дня — результат через месяц
Вчера6 капель в соду — и дезодорант готов: даже в 40-градусную жару подмышки остаются сухими
Вчера


«Тянет по горам с северо-запада»: новороссийцы вновь сняли на видео густой серый дым, накрывший город
15 октября 2018
«Я чувствую себя нормально»: скончавшаяся учительница из Новороссийска почувствовала признаки отравления грибами только спустя сутки
15 октября 2018
Новороссийцы сняли на видео, как из-за ветра опора под козырьком в гипермаркете «Лента» ходит ходуном
15 октября 2018
В Новороссийске 10-летний мальчик упал с пятиметровой высоты: ребенок госпитализирован в тяжелейшем состоянии
15 октября 2018
«Инопланетянин» над Новороссийском: жители города фотографируют и выкладывают в Сеть снимки необычных утренних облаков
15 октября 2018
Жительница Новороссийска поблагодарила водителя маршрутки за неравнодушие
13 октября 2018
В Новороссийске открылась «Гостиная милосердия» в честь святой мученицы Елизаветы Федоровны Романовой: первое видео интерьера
12 октября 2018
Россиянам предложили оплачивать долги за «коммуналку», которые накопили соседи
12 октября 2018
Ярмарка, мастер-классы и угощения: на набережной Новороссийска пройдет праздник ко Дню Кубанского казачества
12 октября 2018
В Новороссийске на стене дома появилось еще одно граффити с изображением небоскребов
12 октября 2018
«Температура 40,2°C »: мамы заболевших детей из станицы Раевской рассказали о массовом заболевании кишечной инфекцией
12 октября 2018
«Рекомендуем пить кипяченую воду»: в Роспотребнадзоре Новороссийска прокомментировали ситуацию с эпидемией кишечной инфекции в станице Раевской
12 октября 2018
В Новороссийске по «горячим следам» задержан подозреваемый в убийстве официантки, тело которой нашли позавчера в Цемесской роще
12 октября 2018
